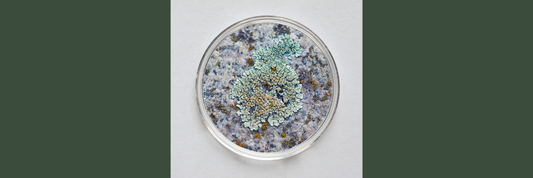

News

Traumschaum mit Nicky!
Schön, dass du meiner Einladung zu einem kleinem Interview gefolgt bist. Bei dir dreht sich alles um feste Kosmetikprodukte, wie feste Shampoos, Duschbars, Badebomben. Erzähl kurz von dir! Was hat...
Traumschaum mit Nicky!
Schön, dass du meiner Einladung zu einem kleinem Interview gefolgt bist. Bei dir dreht sich alles um feste Kosmetikprodukte, wie feste Shampoos, Duschbars, Badebomben. Erzähl kurz von dir! Was hat...

Wie verdünne ich Hochprozentiges?
Alkohol mit Hilfe des Mischungskreuzes in die richtige Verdünnung zu bringen, ist keine Hexerei!
Wie verdünne ich Hochprozentiges?
Alkohol mit Hilfe des Mischungskreuzes in die richtige Verdünnung zu bringen, ist keine Hexerei!
Sprechen wir über Haltbarkeit
Und wie lange hält das DIY-Produkt? Es gibt viele Antworten auf diese Frage. Sehen wir uns das Thema einmal genauer an.
Sprechen wir über Haltbarkeit
Und wie lange hält das DIY-Produkt? Es gibt viele Antworten auf diese Frage. Sehen wir uns das Thema einmal genauer an.

Wie funktioniert ein Emulgator?
Emulgatoren helfen uns, ein Wasser-Öl Gemisch herzustellen und zu stablilisieren. Ganz schön praktisch, aber wie funktioniert das?
Wie funktioniert ein Emulgator?
Emulgatoren helfen uns, ein Wasser-Öl Gemisch herzustellen und zu stablilisieren. Ganz schön praktisch, aber wie funktioniert das?

Rohstoff 101 - Was ist eigentlich D-Panthenol?
Panthenol pflegt nicht nur den wunden Kinderpopo, sondern hilft auch Älteren, die Hautbarriere zu stärken und Wunden rasch zu verheilen.
Rohstoff 101 - Was ist eigentlich D-Panthenol?
Panthenol pflegt nicht nur den wunden Kinderpopo, sondern hilft auch Älteren, die Hautbarriere zu stärken und Wunden rasch zu verheilen.

Haut in den Wechseljahren
Immer noch ein Tabuthema: die Zeit in der die Regelblutung langsam unregelmäßiger und seltener kommt und irgendwann ganz ausbleibt: Die Wechseljahre und Menopause. Mit Anfang der Perimenopause fangen die Eierstöcke...
Haut in den Wechseljahren
Immer noch ein Tabuthema: die Zeit in der die Regelblutung langsam unregelmäßiger und seltener kommt und irgendwann ganz ausbleibt: Die Wechseljahre und Menopause. Mit Anfang der Perimenopause fangen die Eierstöcke...